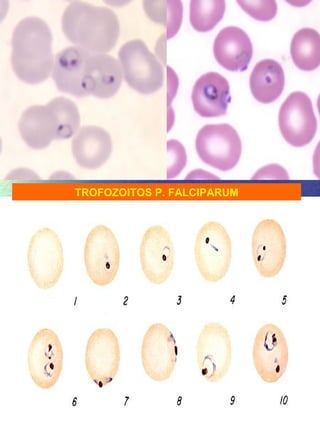
TROFOZOITOS P. FALCIPARUM
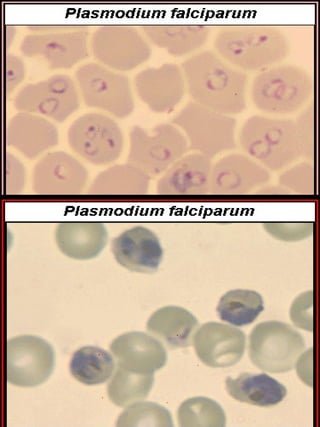
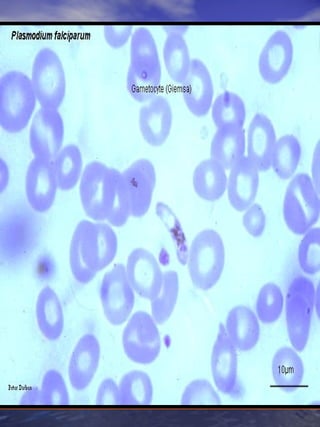
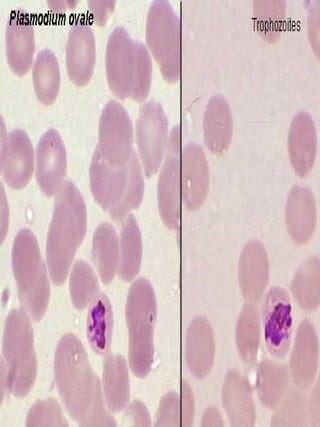
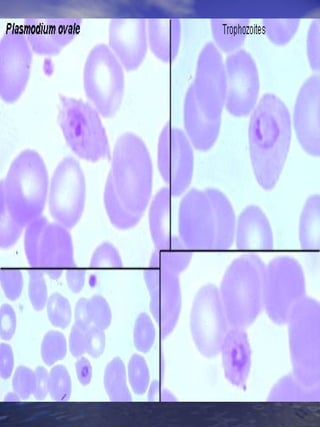
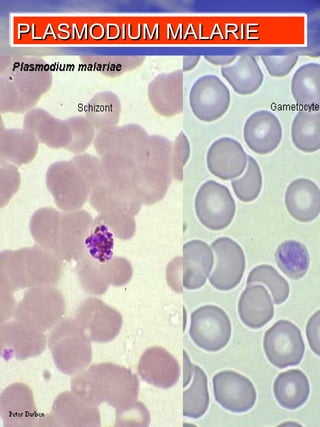
PLASMODIUM MALARIE
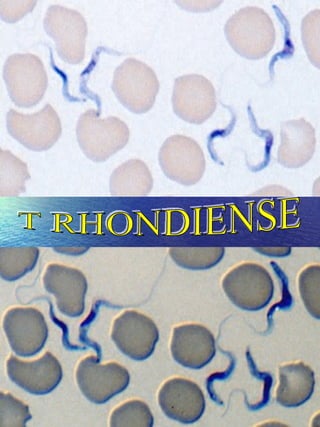
T RHONDIENSE

Embed presentation

























































This document lists different life stages and species of two parasitic protozoa: Leishmania and Plasmodium. It describes the amastigote, promastigote and epimastigote forms of Leishmania and the trophozoite, gametocyte and schizont stages of several Plasmodium species which cause malaria, including P. falciparum, P. ovale, P. malariae, P. vivax, and P. cruzi.